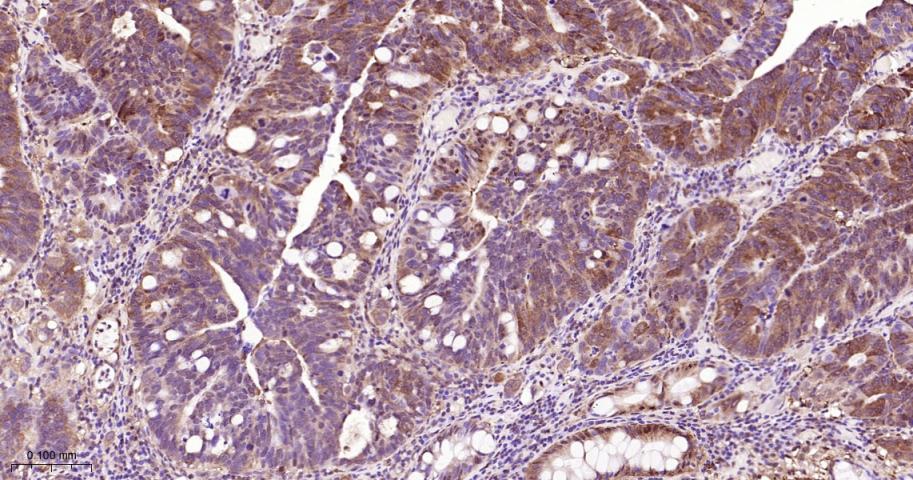
信号转导和转录激活因子3单克隆抗体-bsm-33223M
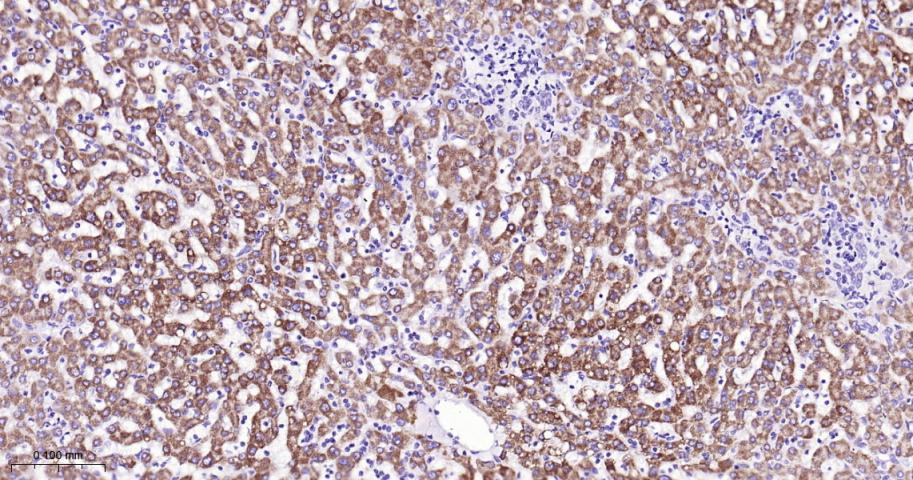
信号转导和转录激活因子3单克隆抗体-bsm-33223M

Cancer > Signal transduction > Nuclear signaling > STAT family
Cardiovascular > Heart > Cardiogenesis > Transcription factors/regulators
Cardiovascular > Heart > Hypertrophy > Transcription factors
Developmental Biology > Embryogenesis > Embryonic stem cells > Surface molecules
Epigenetics and Nuclear Signaling > Nuclear Signaling Pathways > STATs
Epigenetics and Nuclear Signaling > Transcription > Other factors
Microbiology > Organism > Virus > RNA Virus > ssRNA positive strand virus > SARS Coronavirus
Signal Transduction > Signaling Pathway > Nuclear Signaling > STATs

| 应用 | 已检合格种属 | 预测种属 | 推荐稀释比例 |
|---|---|---|---|
| WB | Human, Mouse, Rat | Rabbit | 1:1000-5000 |
| IHC-P | Human | Mouse, Rat, Rabbit | 1:200-2000 |
| IHC-F | Human | Mouse, Rat, Rabbit | 1:200-2000 |
| IF | Human | Mouse, Rat, Rabbit | 1:200-2000 |
交叉反应: Human, Mouse, Rat (predicted: Rabbit)
暂无相关产品